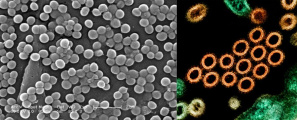

Skvěle, štít %% dosažen
Přejít na téma:
Lidské tělo: mix
Lidské tělo: mix
Přejít na cvičení:
Rozhodovačka
Rozhodovačka
Zobrazit na celou obrazovku
Sdílet
Zobrazit použité zdroje
Zobrazit nastavení cvičení
QR kód
QR kód lze naskenovat např. mobilním telefonem a tak se dostat přímo k danému cvičení nebo sadě příkladů.
Kód / krátká adresa
Tříznakový kód lze napsat do vyhledávacího řádku, také je součástí zkrácené adresy.
Zkopírujte kliknutím.
T4N
umime.to/T4N
Nastavení cvičení
Pozor, nastavení je platné pouze pro toto cvičení a předmět.
Lidské tělo: mix (střední)